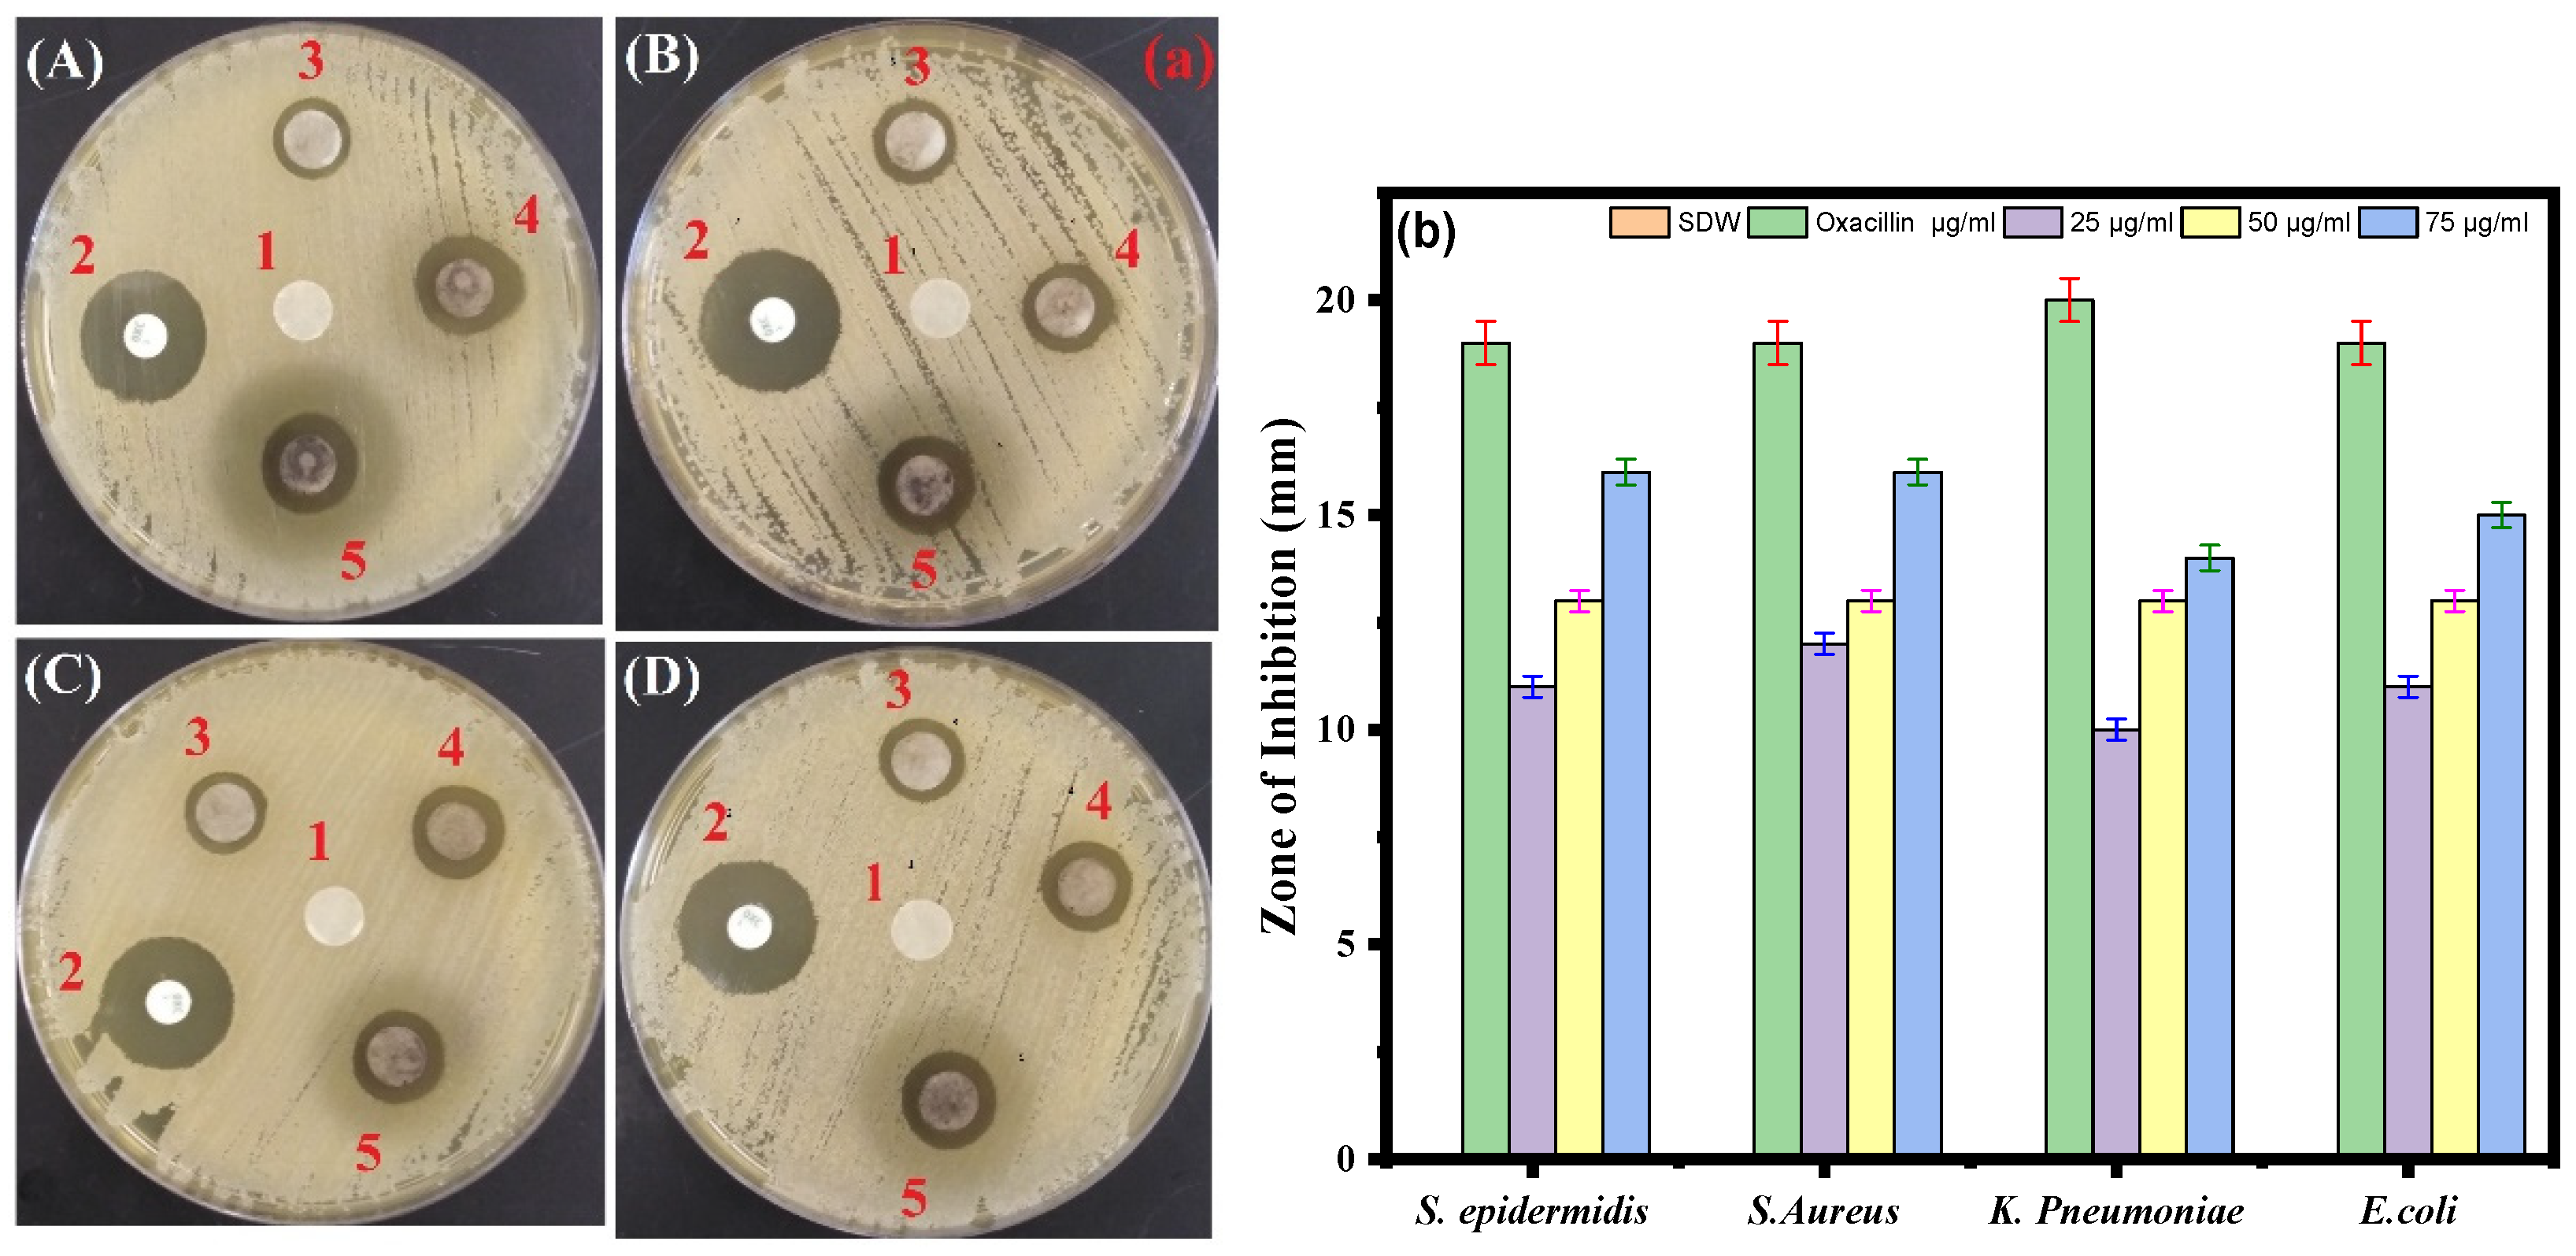
Life 13 00653 g006 Life 13 00653 g006

Biosynthesis of Novel Ag-Cu Bimetallic Nanoparticles from Leaf Extract of Salvia officinalis and Their Antibacterial Activity
Abstract
1. Introduction
2. Materials and Methods
2.1. Materials
2.2. Synthesis of Ag-Cu Bimetallic Nanoparticles
2.3. Characterization of Ag-Cu Bimetallic Nanoparticles
2.4. Bacterial Strain and Growth Conditions
2.5. Minimum Inhibition Concentration (MIC)
2.6. Agar Well Diffusion Assay
2.7. Disk Diffusion Assay
2.8. Biofilm Inhibition Assay
3. Result and Discussions
3.1. UV-Visible and FTIR Spectral Analysis of Ag-Cu NPs
3.2. X-ray Diffraction Analysis
3.3. Surface Morphology Analysis
3.4. Minimum Inhibitory Concentration (MIC) of Ag-Cu NPs
3.5. Antibacterial Activity of Ag-Cu NPs by Agar Well Diffusion Assay
3.6. Disk Diffusion Assay
3.7. Biofilm Inhibition Activity
4. Conclusions
Author Contributions
Funding
Institutional Review Board Statement
Informed Consent Statement
Data Availability Statement
Acknowledgments
Conflicts of Interest
References
- Zhou, M.; Li, C.; Fang, J. Noble-Metal Based Random Alloy and Intermetallic Nanocrystals: Syntheses and Applications. Chem. Rev. 2021, 121, 736–795. [Google Scholar] [CrossRef] [PubMed]
- Toshima, N.; Yonezawa, T. Bimetallic Nanoparticles Novel Materials for Chemical and Physical Applications. New J. Chem. 1998, 22, 1179. [Google Scholar] [CrossRef]
- Föttinger, K.; Rupprechter, G. In Situ Spectroscopy of Complex Surface Reactions on Supported Pd-Zn, Pd-Ga, and Pd(Pt)-Cu Nanoparticles. Acc. Chem. Res. 2014, 47, 3071. [Google Scholar] [CrossRef] [PubMed]
- Mustieles Marin, I.; Asensio, J.M.; Chaudret, B. Bimetallic Nanoparticles Associating Noble Metals and First-Row Transition Metals in Catalysis. ACS Nano 2021, 15, 3550–3556. [Google Scholar] [CrossRef] [PubMed]
- Guo, D.; Xie, G.; Luo, J. Mechanical properties of nanoparticles: Basics and applications. J. Phys. D Appl. Phys. 2013, 47, 013001. [Google Scholar] [CrossRef]
- Holzinger, M.; Le Goff, A.; Cosnier, S. Nanomaterials for biosensing applications: A review. Front. Chem. 2014, 2, 63. [Google Scholar] [CrossRef]
- Alzahrani, E.A.; Nabi, A.; Kamli, M.R.; Albukhari, S.M.; Althabaiti, S.A.; Al-Harbi, S.A.; Khan, I.; Malik, M.A. Facile Green Synthesis of ZnO NPs and Plasmonic Ag-Supported ZnO Nanocomposite for Photocatalytic Degradation of Methylene Blue. Water 2023, 15, 384. [Google Scholar] [CrossRef]
- Loureiro, A.; Azoia, N.G.; Gomes, A.C.; Cavaco-Paulo, A. Albumin-based nanodevices as drug carriers. Curr. Pharm. Des. 2016, 22, 1371–1390. [Google Scholar] [CrossRef]
- Millstone, J.E.; Kavulak, D.F.; Woo, C.H.; Holcombe, T.W.; Westling, E.J.; Briseno, A.L.; Toney, M.F.; Fréchet, J.M. Synthesis, properties, and electronic applications of size-controlled poly (3-hexylthiophene) nanoparticles. Langmuir 2010, 26, 13056–13061. [Google Scholar] [CrossRef]
- Qu, Z.; Liu, P.; Yang, X.; Wang, F.; Zhang, W.; Fei, C. Microstructure and characteristic of BiVO4 prepared under different pH values: Photocatalytic efficiency and antibacterial activity. Materials 2016, 9, 129. [Google Scholar] [CrossRef]
- Sharma, G.; Gupta, V.K.; Agarwal, S.; Kumar, A.; Thakur, S.; Pathania, D. Fabrication and characterization of Fe@ MoPO nanoparticles: Ion exchange behavior and photocatalytic activity against malachite green. J. Mol. Liq. 2016, 219, 1137–1143. [Google Scholar] [CrossRef]
- Mallin, M.P.; Murphy, C.J. Solution-phase synthesis of sub-10 nm Au−Ag alloy nanoparticles. Nano Lett. 2002, 2, 1235–1237. [Google Scholar] [CrossRef]
- Ghosh Chaudhuri, R.; Paria, S. Core/shell nanoparticles: Classes, properties, synthesis mechanisms, characterization, and applications. Chem. Rev. 2012, 112, 2373–2433. [Google Scholar] [CrossRef] [PubMed]
- Wanjala, B.N.; Luo, J.; Fang, B.; Mott, D.; Zhong, C.-J. Gold-platinum nanoparticles: Alloying and phase segregation. J. Mater. Chem. 2011, 21, 4012–4020. [Google Scholar] [CrossRef]
- Wanjala, B.N.; Luo, J.; Loukrakpam, R.; Fang, B.; Mott, D.; Njoki, P.N.; Engelhard, M.; Naslund, H.R.; Wu, J.K.; Wang, L. Nanoscale alloying, phase-segregation, and core−shell evolution of gold−platinum nanoparticles and their electrocatalytic effect on oxygen reduction reaction. Chem. Mater. 2010, 22, 4282–4294. [Google Scholar] [CrossRef]
- Alruqi, S.S.; Al-Thabaiti, S.A.; Malik, M.A.; Khan, Z. Role of surfactants: One step facile synthesis of hetero structured Ag-Ni alloy by seed less approach. Colloids Surf. A Physicochem. Eng. Asp. 2018, 540, 36–47. [Google Scholar] [CrossRef]
- Al-Thabaiti, S.A.; Khan, Z.; Malik, M.A. Bimetallic Ag-Ni nanoparticles as an effective catalyst for hydrogen generation from hydrolysis of sodium borohydride. Int. J. Hydrogen Energy 2019, 44, 16452–16466. [Google Scholar] [CrossRef]
- Alzahrani, S.A.; Malik, M.A.; Al-Thabaiti, S.A.; Khan, Z. Seedless synthesis and efficient recyclable catalytic activity of Ag@ Fe nanocomposites towards methyl orange. Appl. Nanosci. 2018, 8, 255–271. [Google Scholar] [CrossRef]
- Alzahrani, S.A.; Al-Thabaiti, S.A.; Al-Arjan, W.S.; Malik, M.A.; Khan, Z. Preparation of ultra long α-MnO2 and Ag@ MnO2 nanoparticles by seedless approach and their photocatalytic performance. J. Mol. Struct. 2017, 1137, 495–505. [Google Scholar] [CrossRef]
- Khan, Z.; Al-Thabaiti, S.A.; Obaid, A.Y.; Malik, M.A.; Khan, M.N.; Khan, T.A. Cobalt@ silver bimetallic nanoparticles: Solution based seedless surfactant assisted synthesis, optical properties, and morphology. J. Mol. Liq. 2016, 222, 272–278. [Google Scholar] [CrossRef]
- Bankura, K.; Maity, D.; Mollick, M.M.R.; Mondal, D.; Bhowmick, B.; Roy, I.; Midya, T.; Sarkar, J.; Rana, D.; Acharya, K. Antibacterial activity of Ag–Au alloy NPs and chemical sensor property of Au NPs synthesized by dextran. Carbohydr. Polym. 2014, 107, 151–157. [Google Scholar] [CrossRef] [PubMed]
- Wojtysiak, S.; Solla-Gullón, J.; Dłużewski, P.; Kudelski, A. Synthesis of core–shell silver–platinum nanoparticles, improving shell integrity. Colloids Surf. A Physicochem. Eng. Asp. 2014, 441, 178–183. [Google Scholar] [CrossRef]
- Zhang, L.-F.; Zhang, C.-Y. Dodecahedral Au@ Pd nanocrystals with high-index facets and excellent electrocatalytic activity and highly efficient surface-enhanced Raman scattering enhancement. Nanoscale 2013, 5, 6074–6080. [Google Scholar] [CrossRef] [PubMed]
- Benakashani, F.; Allafchian, A.; Jalali, S. Biosynthesis of silver nanoparticles using Capparis spinosa L. leaf extract and their antibacterial activity. Karbala Int. J. Mod. Sci. 2016, 2, 251–258. [Google Scholar] [CrossRef]
- Burdușel, A.-C.; Gherasim, O.; Grumezescu, A.M.; Mogoantă, L.; Ficai, A.; Andronescu, E. Biomedical applications of silver nanoparticles: An up-to-date overview. Nanomaterials 2018, 8, 681. [Google Scholar] [CrossRef]
- Roy, A.; Bulut, O.; Some, S.; Mandal, A.K.; Yilmaz, M.D. Green synthesis of silver nanoparticles: Biomolecule-nanoparticle organizations targeting antimicrobial activity. RSC Adv. 2019, 9, 2673–2702. [Google Scholar] [CrossRef]
- Samari, F.; Salehipoor, H.; Eftekhar, E.; Yousefinejad, S. Low-temperature biosynthesis of silver nanoparticles using mango leaf extract: Catalytic effect, antioxidant properties, anticancer activity and application for colorimetric sensing. New J. Chem. 2018, 42, 15905–15916. [Google Scholar] [CrossRef]
- Venkateswarlu, S.; Kumar, B.N.; Prathima, B.; Anitha, K.; Jyothi, N. A novel green synthesis of Fe3O4-Ag core shell recyclable nanoparticles using Vitis vinifera stem extract and its enhanced antibacterial performance. Phys. B Condens. Matter 2015, 457, 30–35. [Google Scholar] [CrossRef]
- Muralikrishna, T.; Malothu, R.; Pattanayak, M.; Nayak, P. Green synthesis of gold nanoparticles using Mangifera indica (mango leaves) aqueous extract. World J. Nanosci. Technol. 2014, 2, 66–73. [Google Scholar]
- Ahmadi, S.J.; Outokesh, M.; Hosseinpour, M.; Mousavand, T. A simple granulation technique for preparing high-porosity nano copper oxide (II) catalyst beads. Particuology 2011, 9, 480–485. [Google Scholar] [CrossRef]
- Ramgir, N.; Datta, N.; Kaur, M.; Kailasaganapathi, S.; Debnath, A.K.; Aswal, D.; Gupta, S. Metal oxide nanowires for chemiresistive gas sensors: Issues, challenges and prospects. Colloids Surf. A Physicochem. Eng. Asp. 2013, 439, 101–116. [Google Scholar] [CrossRef]
- Borkow, G.; Gabbay, J.; Dardik, R.; Eidelman, A.I.; Lavie, Y.; Grunfeld, Y.; Ikher, S.; Huszar, M.; Zatcoff, R.C.; Marikovsky, M. Molecular mechanisms of enhanced wound healing by copper oxide-impregnated dressings. Wound Repair Regen. 2010, 18, 266–275. [Google Scholar] [CrossRef] [PubMed]
- Borkow, G.; Zatcoff, R.C.; Gabbay, J. Reducing the risk of skin pathologies in diabetics by using copper impregnated socks. Med. Hypotheses 2009, 73, 883–886. [Google Scholar] [CrossRef] [PubMed]
- Gabbay, J.; Borkow, G.; Mishal, J.; Magen, E.; Zatcoff, R.; Shemer-Avni, Y. Copper oxide impregnated textiles with potent biocidal activities. J. Ind. Text. 2006, 35, 323–335. [Google Scholar] [CrossRef]
- Prasad, P.R.; Kanchi, S.; Naidoo, E. In-vitro evaluation of copper nanoparticles cytotoxicity on prostate cancer cell lines and their antioxidant, sensing and catalytic activity: One-pot green approach. J. Photochem. Photobiol. B Biol. 2016, 161, 375–382. [Google Scholar] [CrossRef] [PubMed]
- Stoimenov, P.K.; Klinger, R.L.; Marchin, G.L.; Klabunde, K.J. Metal oxide nanoparticles as bactericidal agents. Langmuir 2002, 18, 6679–6686. [Google Scholar] [CrossRef]
- Umer, A.; Naveed, S.; Ramzan, N.; Rafique, M. Selection of a suitable method for the synthesis of copper nanoparticles. Nano 2012, 7, 1230005. [Google Scholar] [CrossRef]
- Suárez-Cerda, J.; Espinoza-Gómez, H.; Alonso-Núñez, G.; Rivero, I.A.; Gochi-Ponce, Y.; Flores-López, L.Z. A green synthesis of copper nanoparticles using native cyclodextrins as stabilizing agents. J. Saudi Chem. Soc. 2017, 21, 341–348. [Google Scholar] [CrossRef]
- Dutta, S.; Ray, C.; Sarkar, S.; Roy, A.; Sahoo, R.; Pal, T. Facile synthesis of bimetallic Au-Pt, Pd-Pt, and Au-Pd nanostructures: Enhanced catalytic performance of Pd-Pt analogue towards fuel cell application and electrochemical sensing. Electrochim. Acta 2015, 180, 1075–1084. [Google Scholar] [CrossRef]
- Parveen, S.; Sahoo, S.K. Nanomedicine. Clin. Pharmacokinet. 2006, 45, 965–988. [Google Scholar] [CrossRef]
- Pelaz, B.; Alexiou, C.; Alvarez-Puebla, R.A.; Alves, F.; Andrews, A.M.; Ashraf, S.; Balogh, L.P.; Ballerini, L.; Bestetti, A.; Brendel, C. Diverse applications of nanomedicine. ACS Nano 2017, 11, 2313–2381. [Google Scholar] [CrossRef] [PubMed]
- Kabanov, A.; Gendelman, H.E. Nanomedicine in the diagnosis and therapy of neurodegenerative disorders. Prog. Polym. Sci. 2007, 32, 1054–1082. [Google Scholar] [CrossRef] [PubMed]
- Ventola, C.L. The antibiotic resistance crisis: Part 1: Causes and threats. Pharm. Ther. 2015, 40, 277. [Google Scholar]
- Mancuso, G.; Midiri, A.; Gerace, E.; Biondo, C. Bacterial antibiotic resistance: The most critical pathogens. Pathogens 2021, 10, 1310. [Google Scholar] [CrossRef]
- Urban-Chmiel, R.; Marek, A.; Stępień-Pyśniak, D.; Wieczorek, K.; Dec, M.; Nowaczek, A.; Osek, J. Antibiotic Resistance in Bacteria—A Review. Antibiotics 2022, 11, 1079. [Google Scholar] [CrossRef]
- Abebe, G.M. The role of bacterial biofilm in antibiotic resistance and food contamination. Int. J. Microbiol. 2020, 2020, 1705814. [Google Scholar] [CrossRef]
- Zare, H. Effects of Salvia officinalis extract on the breast cancer cell line. SciMed. J. 2019, 1, 25–29. [Google Scholar] [CrossRef]
- Ghorbani, A.; Esmaeilizadeh, M. Pharmacological properties of Salvia officinalis and its components. J. Tradit. Complement. Med. 2017, 7, 433–440. [Google Scholar] [CrossRef]
- Tosun, A.; Khan, S.; Kim, Y.S.; Calín-Sánchez, Á.; Hysenaj, X.; Carbonell-Barrachina, A. Essential oil composition and anti-inflammatory activity of Salvia officinalis L (Lamiaceae) in murin macrophages. Trop. J. Pharm. Res. 2014, 13, 937–942. [Google Scholar] [CrossRef]
- Oalđe Pavlović, M.; Kolarević, S.; Đorđević, J.; Jovanović Marić, J.; Lunić, T.; Mandić, M.; Kračun Kolarević, M.; Živković, J.; Alimpić Aradski, A.; Marin, P.D. A study of phytochemistry, genoprotective activity, and antitumor effects of extracts of the selected Lamiaceae species. Plants 2021, 10, 2306. [Google Scholar] [CrossRef]
- Sharma, Y.; Fagan, J.; Schaefer, J. Ethnobotany, phytochemistry, cultivation and medicinal properties of Garden sage (Salvia officinalis L.). J. Pharmacogn. Phytochem. 2019, 8, 3139–3148. [Google Scholar]
- Bodnar Willard, M.A.; McGuffin, V.L.; Waddell Smith, R. Forensic analysis of Salvia divinorum using multivariate statistical procedures. Part I: Discrimination from related Salvia species. Anal. Bioanal. Chem. 2012, 402, 833–842. [Google Scholar] [CrossRef] [PubMed]
- Capek, P.; Hřıíbalová, V. Water-soluble polysaccharides from Salvia officinalis L. possessing immunomodulatory activity. Phytochemistry 2004, 65, 1983–1992. [Google Scholar] [CrossRef] [PubMed]
- Lu, Y.; Foo, L.Y. Flavonoid and phenolic glycosides from Salvia officinalis. Phytochemistry 2000, 55, 263–267. [Google Scholar] [CrossRef] [PubMed]
- Mitić-Ćulafić, D.; Vuković-Gačić, B.S.; Knežević-Vukčević, J.B.; Stanković, S.; Simić, D.M. Comparative study on the antibacterial activity of volatiles from sage (Salvia officinalis L.). Arch. Biol. Sci. 2005, 57, 173–178. [Google Scholar] [CrossRef]
- Kontogianni, V.G.; Tomic, G.; Nikolic, I.; Nerantzaki, A.A.; Sayyad, N.; Stosic-Grujicic, S.; Stojanovic, I.; Gerothanassis, I.P.; Tzakos, A.G. Phytochemical profile of Rosmarinus officinalis and Salvia officinalis extracts and correlation to their antioxidant and anti-proliferative activity. Food Chem. 2013, 136, 120–129. [Google Scholar] [CrossRef]
- Taner, M.; Sayar, N.; Yulug, I.G.; Suzer, S. Synthesis, characterization and antibacterial investigation of silver–copper nanoalloys. J. Mater. Chem. 2011, 21, 13150–13154. [Google Scholar] [CrossRef]
- Navas, M.; Soni, R. Laser-generated bimetallic Ag-Au and Ag-Cu core-shell nanoparticles for refractive index sensing. Plasmonics 2015, 10, 681–690. [Google Scholar] [CrossRef]
- Liu, Y.; Kim, S.; Kim, Y.J.; Perumalsamy, H.; Lee, S.; Hwang, E.; Yi, T.H. Green synthesis of gold nanoparticles using Euphrasia officinalisleaf extract to inhibit lipopolysaccharide-induced inflammation through NF-κB and JAK/STAT pathways in RAW 264.7 macrophages. Int. J. Nanomed. 2019, 14, 2945–2959. [Google Scholar] [CrossRef]
- Kobayashi, Y.; Maeda, T.; Yasuda, Y.; Morita, T. Metal–metal bonding using silver/copper nanoparticles. Appl. Nanosci. 2016, 6, 883–893. [Google Scholar] [CrossRef]
- Valodkar, M.; Jadeja, R.N.; Thounaojam, M.C.; Devkar, R.V.; Thakore, S. Biocompatible synthesis of peptide capped copper nanoparticles and their biological effect on tumor cells. Mater. Chem. Phys. 2011, 128, 83–89. [Google Scholar] [CrossRef]
- Kamli, M.R.; Malik, M.A.; Srivastava, V.; Sabir, J.S.; Mattar, E.H.; Ahmad, A. Biogenic ZnO Nanoparticles Synthesized from Origanum vulgare Abrogates Quorum Sensing and Biofilm Formation in Opportunistic Pathogen Chromobacterium violaceum. Pharmaceutics 2021, 13, 1743. [Google Scholar] [CrossRef] [PubMed]
- Gudkov, S.V.; Serov, D.A.; Astashev, M.E.; Semenova, A.A.; Lisitsyn, A.B. Ag2O Nanoparticles as a Candidate for Antimicrobial Compounds of the New Generation. Pharmaceuticals 2022, 15, 968. [Google Scholar] [CrossRef] [PubMed]
- Zia, R.; Riaz, M.; Farooq, N.; Qamar, A.; Anjum, S. Antibacterial activity of Ag and Cu nanoparticles synthesized by chemical reduction method: A comparative analysis. Mater. Res. Express 2018, 5, 075012. [Google Scholar] [CrossRef]
- Fan, X.; Yahia, L.H.; Sacher, E. Antimicrobial properties of the Ag, Cu nanoparticle system. Biology 2021, 10, 137. [Google Scholar] [CrossRef] [PubMed]
- Valodkar, M.; Modi, S.; Pal, A.; Thakore, S. Synthesis and antibacterial activity of Cu, Ag and Cu–Ag alloy nanoparticles: A green approach. Mater. Res. Bull. 2011, 46, 384–389. [Google Scholar] [CrossRef]
- Lange, A.; Grzenia, A.; Wierzbicki, M.; Strojny-Cieslak, B.; Kalińska, A.; Gołębiewski, M.; Radzikowski, D.; Sawosz, E.; Jaworski, S. Silver and copper nanoparticles inhibit biofilm formation by mastitis pathogens. Animals 2021, 11, 1884. [Google Scholar] [CrossRef]

| Strains | Ag-Cu NPs MIC (µg/mL) | Amoxicillin MIC (µg/mL) |
|---|---|---|
| Klebsiella pneumoniae | 10 | 2 |
| Escherichia coli | 15 | 2 |
| Staphylococcus aureus | 5 | 2 |
| Staphylococcus epidermidis | 5 | 2 |
Disclaimer/Publisher’s Note: The statements, opinions and data contained in all publications are solely those of the individual author(s) and contributor(s) and not of MDPI and/or the editor(s). MDPI and/or the editor(s) disclaim responsibility for any injury to people or property resulting from any ideas, methods, instructions or products referred to in the content. |
© 2023 by the authors. Licensee MDPI, Basel, Switzerland. This article is an open access article distributed under the terms and conditions of the Creative Commons Attribution (CC BY) license (https://creativecommons.org/licenses/by/4.0/).
Share and Cite
Malik, M.A.; Albeladi, S.S.; Al-Maaqar, S.M.; Alshehri, A.A.; Al-Thabaiti, S.A.; Khan, I.; Kamli, M.R. Biosynthesis of Novel Ag-Cu Bimetallic Nanoparticles from Leaf Extract of Salvia officinalis and Their Antibacterial Activity. Life 2023, 13, 653. https://doi.org/10.3390/life13030653
Malik MA, Albeladi SS, Al-Maaqar SM, Alshehri AA, Al-Thabaiti SA, Khan I, Kamli MR. Biosynthesis of Novel Ag-Cu Bimetallic Nanoparticles from Leaf Extract of Salvia officinalis and Their Antibacterial Activity. Life. 2023; 13(3):653. https://doi.org/10.3390/life13030653
Chicago/Turabian StyleMalik, Maqsood Ahmad, Shroog ShdiedRoyji Albeladi, Saleh Mohammed Al-Maaqar, Abdulmohsen Ali Alshehri, Shaeel Ahmed Al-Thabaiti, Imran Khan, and Majid Rasool Kamli. 2023. "Biosynthesis of Novel Ag-Cu Bimetallic Nanoparticles from Leaf Extract of Salvia officinalis and Their Antibacterial Activity" Life 13, no. 3: 653. https://doi.org/10.3390/life13030653
APA StyleMalik, M. A., Albeladi, S. S., Al-Maaqar, S. M., Alshehri, A. A., Al-Thabaiti, S. A., Khan, I., & Kamli, M. R. (2023). Biosynthesis of Novel Ag-Cu Bimetallic Nanoparticles from Leaf Extract of Salvia officinalis and Their Antibacterial Activity. Life, 13(3), 653. https://doi.org/10.3390/life13030653

